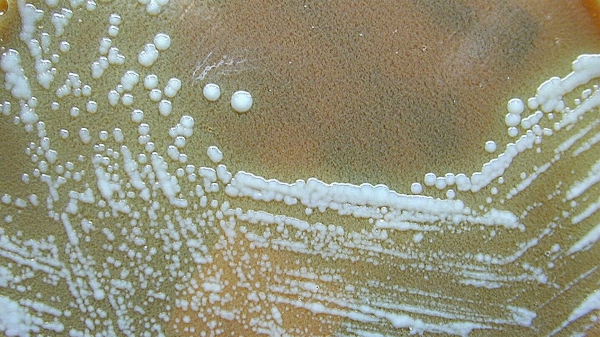
Туляремия: симптомы, переносчики, профилактика и лечение болезни Туляремия: симптомы, переносчики, профилактика и лечение болезни

- Туляремия
- Случаи заболевания в Карелии
- Характеристика возбудителя
- Переносчики
- Как происходит заражение
- Симптомы
- Формы заболевания
- Степени тяжести
- Осложнения и последствия
- Диагностика
- Лечение
- Вакцинация
- Профилактика
- Рекомендации врачей
Туляремия. Посев культуры Francisella tularensisОглавление
- Туляремия
- Случаи заболевания в Карелии
- Характеристика возбудителя
- Переносчики
- Как происходит заражение
- Симптомы
- Формы заболевания
- Степени тяжести
- Осложнения и последствия
- Диагностика
- Лечение
- Вакцинация
- Профилактика
- Рекомендации врачей
Туляремия, или малая чума — это острое инфекционное заболевание, возбудителем которого является бактерия Francisella tularensis. Болезнь сопровождается лихорадкой, интоксикацией и поражением лимфатических узлов. Об основных формах болезни, переносчиках инфекции, симптомах, а также методах диагностики и лечения — в материале РИА Новости.Туляремия
Туляремия — это природно-очаговое острое инфекционное заболевание, которое чаще всего встречается в сельской местности. Болезнь поражает лимфатические узлы, кожу, иногда слизистые оболочки глаз, а также зев, легкие и кишечник.
“Туляремия является редким, но крайне опасным заболеванием. Им могут заразиться и животные, и человек. Если не лечиться, то туляремия способна привести к серьезным осложнениям и даже к смерти”, — рассказала РИА Новости врач-терапевт Светлана Михайловская.

Туляремическое поражение кожи правой руки
В группу риска туляремии входят:
- охотники;
- ветеринары;
- рыболовы;
- сотрудники приютов для животных;
- работники сферы животноводства;
- пастухи;
- повара;
- сельхозработники и др.
Природные очаги туляремии встречаются повсеместно, но чаще всего в умеренном климатическом поясе Северного полушария. В России болезнь впервые зарегистрировали в 1926 году в низовьях Волги близ Астрахани. В 90-е годы численность заболевших колебалась от 100 до 400 человек в год, при этом вспышки регистрировались в Республике Башкортостан, Ростовской, Смоленской и Оренбургской областях, а также в Москве. Самая крупная вспышка случилась в 2013 году — тогда в Ханты-Мансийске туляремией заразилось 840 человек. Эксперты отмечают, что рост заболеваемости наблюдается из-за увеличения численности грызунов и во время сенокоса и уборочных работ.
Источник: ria.ru